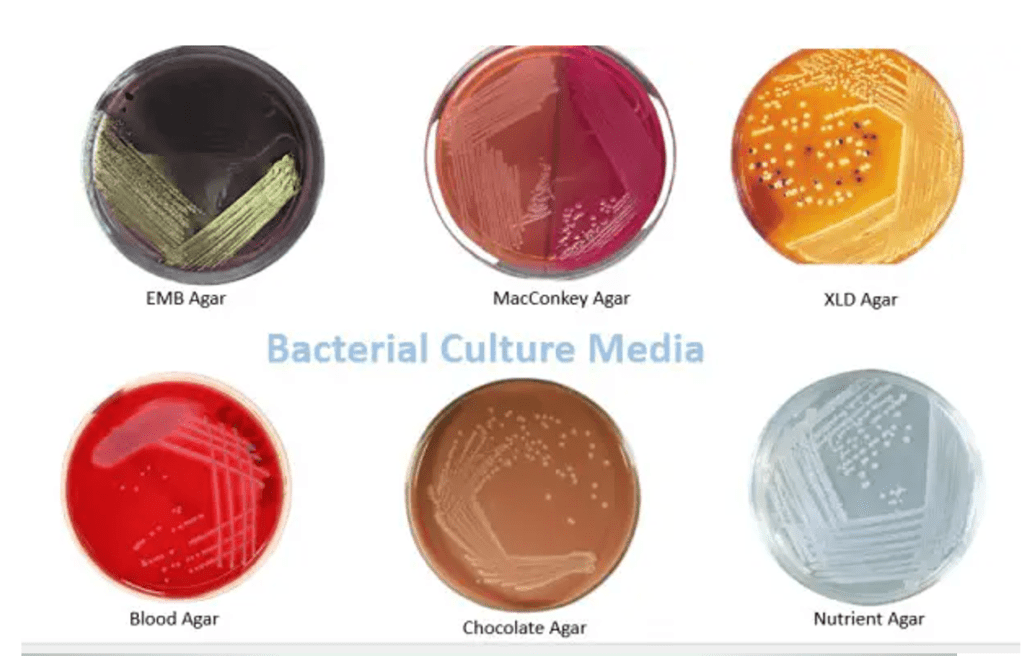
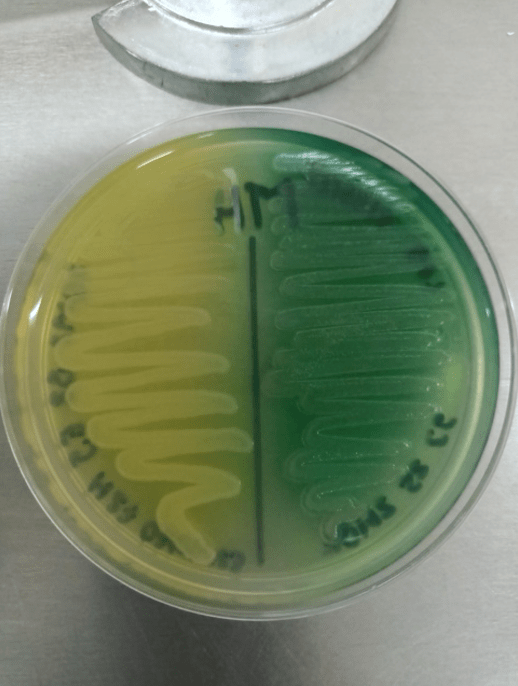

Foundation A
Question 1)
Answer: a) The average number of new infections generated by a single infected individual in a completely susceptible population.
Explanation: R₀ represents the potential for disease spread in a population where everyone is susceptible. It estimates how many people one infected person will infect on average in such a population regardless of immunity or any intervention.
B is incorrect as it is describing the net reproductive number Rₙ which represents the potential for disease spread in a population with some immunity and interventions like vaccine or quarantine.
Question 2)
Answer: c) Endemic
Explanation:
A is incorrect as Epidemic refers to a sudden increase in cases above the normal level in a specific region.
B is incorrect as Pandemic describes a disease that spreads over multiple countries or continents.
D is incorrect as Outbreak can describe any sudden increase in cases but is not necessarily consistent.
E is incorrect as Sporadic refers to isolated, occasional or cases by chance rather than a consistent pattern.
Question 3)
Answer: a) Represents the potential for disease spread in a population with some immunity and interventions.
Explanation: Rₙ considers the proportion of immune individuals and interventions, reflecting a more realistic scenario of disease spread.
B is incorrect as Measures the number of new infections in a completely susceptible population describes the basic reproductive number R₀, not the net reproductive number Rₙ.
C is incorrect as Reflects the proportion of susceptible individuals does not refer to Rₙ.
D is incorrect as Rₙ measures potential spread, not outbreak severity.
E is incorrect although Rₙ can be influenced by vaccination, it doesn’t directly measure vaccine effectiveness.
Question 4)
Answer: c) Direct contact with infected individuals
Explanation: Vehicle transmission involves pathogens transmitted via contaminated inanimate objects or substances, not direct contact.
A is incorrect as Contaminated water involves vehicle transmission through water.
B is incorrect as Airborne particles involve vehicle transmission through air, but more commonly refers to aerosolized particles rather than solid objects.
D is incorrect as Contaminated food involves vehicle transmission through food.
E is incorrect as Contaminated surfaces (fomites) involve vehicle transmission through surfaces contaminated with pathogens.
Question 5)
Answer: c) Vertical transmission
Explanation:
A is incorrect as Horizontal transmission refers to transmission between individuals of the same generation e.g. by direct contact.
B is incorrect as Fomite transmission refers to transmission through contaminated inanimate objects.
D is incorrect as Vector transmission refers to transmission by insects or other animals.
E is incorrect as Airborne transmission refers to spread through air particles.
Question 6)
Answer: b) Increased clotting and bleeding due to excessive coagulation factors and fibrin formation.
Explanation: DIC involves widespread clotting throughout small blood vessels, leading to both clot formation and bleeding due to consumption of clotting factors.
A Reduced clotting due to a deficiency in coagulation factors is incorrect as DIC involves excessive clotting, not reduced clotting, it can at later stages encourage bleeding as there are no clotting factors left to clot the blood.
C Inhibition of the immune response is incorrect as DIC is related to coagulation, not immune response.
D Increased production of white blood cells is incorrect as DIC is related to clotting and platelets, not white blood cell production.
E Decreased blood flow to vital organs due to vascular collapse is incorrect as DIC involves clotting and bleeding rather than direct vascular collapse.
Question 7)
Answer: d) Organisms that live inside the cells or tissues of another organism in a mutually beneficial relationship.
Explanation:
A is incorrect as Organisms living in close association with other organisms but outside their cells describes ectosymbionts or commensals.
B is incorrect as Microorganisms that live on the surface of other organisms without causing harm describes commensals or ectosymbionts.
C is incorrect as Pathogens that spread through contaminated food and water describes vehicle transmission, not endosymbionts.
E is incorrect as Inanimate objects that carry infectious agents describes fomites.
Question 8)
Answer: C) Streptococcus pyogenes
Explanation: Streptococcus pyogenes, also known as Group A Streptococcus (GAS), is a Gram-positive cocci that grows in chains. S. pyogenes is commonly found in the throat and on the skin. Many people can carry the bacteria asymptomatically, especially in the throat, without developing an infection. It causes pharyngitis (strep throat), skin infections (impetigo, erysipelas), and more serious conditions such as rheumatic fever or post-streptococcal glomerulonephritis following untreated strep throat. It can also cause invasive diseases like necrotizing fasciitis (“flesh-eating disease”) and streptococcal toxic shock syndrome when it spreads deeper into tissues or the bloodstream. It becomes pathogenic when it invades tissues or organs, often following a breach of natural barriers (such as broken skin or mucous membranes). This can occur when the immune system is weakened or when there is close contact with an infected person. It can also lead to scarlet fever, impetigo, cellulitis, and more severe invasive diseases like necrotizing fasciitis and streptococcal toxic shock syndrome.
A is incorrect as Staphylococcus aureus is a Gram-positive coccus that forms clusters and is facultatively anaerobic. S. aureus is commonly found in the anterior nares (nostrils) of about 30% of healthy individuals, making it a frequent colonizer of the nasal passages. It can also be found on the skin and mucous membranes, but the nares are the primary colonization site. It can sometimes be present on other body surfaces, such as the armpits or groin and can cause serious conditions like pneumonia, endocarditis, osteomyelitis, and toxic shock syndrome. It is not a common cause of throat infections, though in rare cases, it may be found in tonsillitis. It produces several virulence factors, including toxins like the toxic shock syndrome toxin (TSST) and exfoliative toxins.
B is incorrect as Streptococcus pneumoniae is a Gram-positive, encapsulated, lancet-shaped diplococcus. S. pneumoniae commonly resides in the nasopharynx (upper part of the throat behind the nose) of healthy carriers, especially in children. It becomes pathogenic when the immune system is weakened, or when it spreads to areas where it is not normally found, such as the lungs, ears, sinuses, or bloodstream. In these situations, it can cause pneumonia, otitis media, sinusitis, meningitis, or sepsis. Though it can affect the upper respiratory tract, it is more commonly associated with infections lower down, such as pneumonia.
D is incorrect as Escherichia coli is a Gram-negative, facultatively anaerobic rod-shaped bacterium. E. coli is normally found in the intestines of humans and animals, where it forms part of the gut flora and helps with digestion. Most strains of E. coli are harmless, but some can acquire virulence factors that make them pathogenic. It also becomes pathogenic outside the gut, such as in the urinary tract, where it is the leading cause of urinary tract infections (UTIs), or in the bloodstream, where it can cause sepsis and meningitis in neonates
E is incorrect as Haemophilus influenzae is a small, Gram-negative, coccobacillary, facultative anaerobe. H. influenzae is found in the upper respiratory tract, particularly in the nasopharynx of healthy individuals. It is part of the normal flora in some people, especially children. It becomes pathogenic when it spreads from the nasopharynx to other parts of the body, such as the middle ear, sinuses, lungs, or bloodstream.It can cause upper respiratory tract infections, but it is more often linked to otitis media, sinusitis, epiglottitis, and pneumonia. In the past, H. influenzae type b (Hib) was a leading cause of paediatric meningitis before the introduction of the Hib vaccine.
Question 9)
Answer: D) Both B and C
Explanation: Ziehl Neelsen stain is highly effective for identifying M. tuberculosis, as it resists decolorization due to its thick, waxy cell wall. Acid-fast staining, such as the Ziehl-Neelsen technique, is commonly used in clinical settings to detect tuberculosis in sputum and other specimens. It highlights acid-fast bacilli, which do not stain well with regular techniques. Culturing for acid-fast bacilli (AFB) involves growing M. tuberculosis in a controlled environment to confirm its presence. Since M. tuberculosis grows slowly, cultures can take several weeks to yield results. While slower than some other methods, culturing is considered the gold standard for tuberculosis diagnosis. It is highly sensitive and allows for testing of drug susceptibility, which is important for treatment planning. Cultures are often done in conjunction with staining techniques.
A is incorrect as the Gram stain is a commonly used staining technique to classify bacteria as Gram-positive or Gram-negative based on the composition of their cell walls. Mycobacterium tuberculosis (the causative agent of tuberculosis) does not stain well with the Gram stain due to its unique cell wall,
E is incorrect as although PCR is a highly sensitive and specific test that can rapidly detect M. tuberculosisin clinical samples, even when there are only small amounts of bacteria present, it is not yet as widely available or routinely used as staining and culture, which remain more common in many parts of the world. PCR is often used as an adjunct to other tests.
Question 10)
Answer: B) They help maintain the structural integrity of the cell wall.
Explanation: Teichoic acids are polymers that are embedded in the peptidoglycan layer of the GRAM POSITIVE bacterial cell wall, they help maintain the cell wall’s integrity and shape, they play a role in cell growth and division. Teichoic acids can mediate adherence to host tissues, contributing to the virulence of certain bacteria and they can serve as antigens, helping the immune system recognize the bacteria.
A is incorrect teichoic acids are part of the cell wall, not the capsule. Some bacteria do have a capsule, but it is made of polysaccharides such as peptidoglycan, not teichoic acids and the capsule helps in evading the immune system by preventing phagocytosis. Teichoic acids are components of the cell wall, not the capsule.
C is incorrect as teichoic acids are not involved in bacterial movement. Flagella enable motility.
D is incorrect as teichoic acids do not participate in respiration.
E is incorrect as teichoic acids help stabilize the cell wall but are not enzymes that break down peptidoglycan. The breakdown of peptidoglycan is performed by enzymes such as autolysins and lysozymes, not teichoic acids.
Question 11)
Answer: B) Gram-positive, cocci, and facultative anaerobic
Explanation: Staphylococcus aureus is a Gram-positive cocci that typically appears in clusters resembling grapes. It is facultatively anaerobic, which means it can grow in both aerobic and anaerobic environments. This flexibility allows it to thrive in various body sites.
A is incorrect because Staphylococcus aureus is Gram-positive, not Gram-negative.
C is incorrect because it is not bacilli; it is cocci.
D is incorrect because Staphylococcus aureus is not Gram-negative and is not strictly aerobic.
E is incorrect because, while it is Gram-positive and cocci, it is not strict aerobic; it can grow in low-oxygen environments.
Question 12)
Answer: C) Cause alpha-haemolysis on blood agar
Explanation: Streptococcus pneumoniae is a Gram-positive cocci, typically appearing in pairs (diplococci) or chains. It is alpha-haemolytic, meaning it partially lyses red blood cells in blood agar, producing a greenish discoloration around the colonies. This organism is a major cause of community-acquired pneumonia, meningitis, and otitis media. It possesses a polysaccharide capsule that helps evade phagocytosis, making it particularly virulent.
A is incorrect because it does not ferment lactose; lactose fermentation is more associated with Enterobacteriaceae.
B is incorrect as it does not hydrolyse urea; this is a feature of some other organisms.
D is incorrect since Streptococcus pneumoniae does not grow well in high salt concentrations, which is a characteristic of Enterococcus.
E is incorrect because while it has a capsule, it is not visible under light microscopy without specific staining techniques.
Question 13)
Answer: A) Antibiotic-associated diarrhoea
Explanation: Clostridium difficile is the leading cause of antibiotic-associated diarrhoea, as antibiotic disrupt normal gut flora. The bacteria produce toxins (toxin A and toxin B) that damage the colonic mucosa, leading to inflammation and diarrhoea. Severe cases can progress to pseudomembranous colitis, characterized by inflammation of the colon and formation of pseudomembranes.
B is incorrect as infective endocarditis is usually caused by organisms like Staphylococcus aureus or Streptococcus viridians.
C is incorrect because necrotizing fasciitis is more associated with Streptococcus pyogenes or Staphylococcus aureus.
D is incorrect; viral gastroenteritis is caused by viruses such as norovirus or rotavirus, not Clostridium difficile.
E is incorrect because chronic sinusitis is not linked to Clostridium difficile.
Question 14)
Answer: B) Dimorphic fungus that can exist as yeast and filamentous form
Explanation: Candida albicans is a dimorphic fungus that can exist in both yeast and filamentous (mould) forms. This dimorphism is significant for its pathogenicity, allowing it to adapt to various environments within the host. It is typically a part of the normal flora of the human body but can cause opportunistic infections, particularly in immunocompromised individuals. Common infections include oral thrush, vaginitis, and systemic candidiasis.
A is incorrect because Candida albicans is not Gram-negative; it is a fungus that does not typically fit this classification.
C is incorrect as Candida albicans is not an obligate anaerobe; it can grow in the presence of oxygen.
D is incorrect because it does exhibit dimorphism, switching between yeast and mould forms.
E is incorrect because it is not bacilli; it is a fungus.
Question 15)
Answer: B) Inhalation of aerosolised spores
Explanation: Histoplasma capsulatum is a fungus primarily transmitted through the inhalation of aerosolised spores found in environments contaminated with bird or bat droppings. Once inhaled, the spores can convert to yeast form in the human body, leading to pulmonary histoplasmosis. The infection can range from asymptomatic to severe, depending on the immune status of the individual, it is usually very severe in immunocompromised people
A is incorrect because Histoplasma is not transmitted via food.
C is incorrect as direct contact with skin lesions is not a common transmission route for this fungus.
D is incorrect since blood transfusion is not a method of transmission for Histoplasma.
E is incorrect because sexual contact does not facilitate the transmission of this organism.
Question 16)
Answer: D) Cryptococcus neoformans
Explanation: The clinical presentation of headache, fever, photophobia, and the findings of increased opening pressure and cryptococcal antigen positivity in the cerebrospinal fluid strongly indicate an infection with Cryptococcus neoformans. This organism is known for causing cryptococcal meningitis, particularly in immunocompromised patients like those with HIV. The polysaccharide capsule is a key diagnostic feature and can be detected in CSF. The organism is often found in pigeon droppings and can be inhaled, leading to pulmonary infection and potentially disseminating to the central nervous system causing meningitis
A is incorrect because Histoplasma capsulatum typically causes respiratory symptoms and can also affect the CNS but does not produce cryptococcal antigen.
B is incorrect as Candida albicans primarily causes mucosal infections and not meningitis.
C is incorrect; Coccidioides immitis is associated with Valley fever and does not typically present with these specific symptoms.
E is incorrect because Aspergillus fumigatus usually causes pulmonary infections rather than meningitis.
Question 17)
Answer: D) Protozoan
Explanation: Plasmodium falciparum is a protozoan parasite belonging to the genus Plasmodium. It is responsible for the most severe form of malaria. The lifecycle consists of two main phases:
Mosquito Phase: The female Anopheles mosquito bites a human and ingests blood containing gametocytes. Inside the mosquito, gametocytes develop into male and female gametes, which fertilize to form a zygote. The zygote transforms into an ookinete, which penetrates the mosquito’s midgut wall and forms an oocyst. The oocyst undergoes asexual reproduction, producing sporozoites, which migrate to the mosquito’s salivary glands. When the mosquito bites again, these sporozoites enter the human bloodstream.
Human Phase: Once in the human body, sporozoites travel to the liver, where they invade hepatocytes (liver cells) and undergo asexual replication, forming thousands of merozoites. These merozoites are released into the bloodstream, where they invade red blood cells. Inside red blood cells, the merozoites continue to replicate, leading to the lysis of the cells and the release of more merozoites. Some merozoites develop into gametocytes, which can be taken up by another mosquito, thus continuing the lifecycle.
A is incorrect because bacteria are prokaryotic organisms that lack a nucleus and are different from eukaryotic protozoa.
B is incorrect as fungi are also eukaryotic but belong to a different kingdom. Plasmodium is a protozoan, not a fungus.
C is incorrect as helminths are multicellular worms, such as tapeworms (cestode) and roundworms (nematodes), whereas Plasmodium is unicellular.
E is incorrect as viruses are acellular entities that require a host to replicate, while Plasmodium has its own cellular structure and life cycle.
Question 18)
Answer: B) Diabetes mellitus
Explanation: Diabetes mellitus, particularly when poorly controlled or complicated by diabetic ketoacidosis (DKA), significantly increases the risk of developing mucormycosis. The elevated blood sugar levels and acidic environment impair the immune response, providing a favourable environment for mucoromycetes. Mucormycosis often starts in the sinuses and can quickly spread to the brain, leading to severe complications.
A is incorrect as the advanced age can increase susceptibility to infections but is not a specific risk factor for mucormycosis compared to diabetes.
C is incorrect as although recent surgery can pose infection risks, diabetes significantly enhances susceptibility to mucormycosis.
D is incorrect as although pregnancy may cause immune changes, it is not a primary risk factor for mucormycosis compared to diabetes.
E is incorrect as although Asthma patients may be more prone to respiratory infections, it does not specifically increase the risk for mucormycosis compared to the effects of diabetes.
Question 19)
Answer: D) Fly larvae
Explanation: Myiasis is an infestation caused by the larvae of certain fly species that develop in the tissues of a host organism. These larvae can feed in a subdermal cavity, typically for 5-10 weeks, breathing through a hole in the host’s skin. The infection can occur when flies lay eggs on or near a wound, or in areas of the body with moisture.
A is incorrect as Taenia solium is a cestode (tapeworm) that causes cysticercosis and taeniasis. Infection occurs primarily through the ingestion of undercooked pork that contains cysticerci (larval forms). It can lead to serious complications, especially when larvae migrate to the brain, causing neurocysticercosis.
B is incorrect as Strongyloides stercoralis is a nematode (roundworm) that causes strongyloidiasis. It typically infects humans through skin penetration by larvae found in contaminated soil, especially in tropical regions. In immunocompromised individuals, it can lead to severe infections.
C is incorrect as Dermatophytes are fungi that cause skin infections such as ringworm and tinea. They thrive in warm, moist environments and can infect the skin, hair, and nails, but they are not responsible for myiasis.
E is incorrect as Plasmodium falciparum is a protozoan parasite that causes malaria. It is transmitted to humans through the bites of infected Anopheles mosquitoes. While it is a significant pathogen, it does not relate to myiasis.
Question 20)
Answer: B) Trematode associated with bilharzia
Explanation: Schistosoma spp. are trematodes (flatworms) responsible for schistosomiasis, also known as bilharzia. This disease results from the penetration of the skin by cercariae (larval forms) present in contaminated freshwater. The lifecycle involves freshwater snails as intermediate hosts, where the larvae develop before infecting humans. Symptoms can include abdominal pain, diarrhoea, and blood in urine, with potential long-term complications such as liver damage.
A is incorrect because cestodes are tapeworms (e.g., Taenia spp.), not flatworms like Schistosoma.
C is incorrect as nematodes are roundworms (e.g., Strongyloides), while Schistosoma is a flatworm.
D is incorrect because Schistosoma is not a protozoan but a trematode. Protozoa like Plasmodium have different lifecycles involving different hosts.
E is incorrect because schistosomes use snails as intermediate hosts, not arthropods.
Question 21)
Answer: C) Immunosuppression
Explanation: Aspergillus species are ubiquitous moulds that can cause serious infections, particularly in individuals who are immunocompromised. Common risk factors include hematologic malignancies (cancers of blood-forming tissues), solid organ transplants, and corticosteroid use, which all impair the immune system. Aspergillus can lead to invasive aspergillosis, characterized by the mould invading blood vessels and causing tissue necrosis.
A is incorrect as although Diabetes can increase the risk of some infections, it is more associated with mucormycosis than with Aspergillus.
B is not the best answer as HIV/AIDS are somewhat relevant, but immunosuppression broadly is more encompassing of various conditions and treatments that significantly increase susceptibility to Aspergillus infections.
D is incorrect as although recent surgery can increase infection risks, it is not specific to Aspergillus.
E is incorrect as although pregnant women may have altered immune responses, they are not specifically at higher risk for Aspergillus infections compared to immunocompromised patients.
Question 22)
Answer: C) Bind to the 30S ribosomal subunit, causing mRNA misreading
Explanation: Aminoglycosides, such as gentamicin, amikacin, and streptomycin, are antibiotics that work by disrupting bacterial protein synthesis. Bacterial ribosomes are made of two subunits: the 50S (large) and 30S (small) subunits. Aminoglycosides target the 30S subunit. They bind specifically to the 30S subunit. This binding is critical because it disrupts how the ribosome reads the bacterial mRNA. Normally, ribosomes “read” the mRNA and translate it into proteins by matching codons to the correct amino acids. When aminoglycosides bind to the 30S subunit, they cause misreading of the mRNA. This leads to incorrect codon-anticodon pairing. As a result, the bacterial ribosome adds the wrong amino acids into the growing protein chain. The misreading results in the production of non-functional or harmful proteins, which ultimately causes cell lysis. Aminoglycosides are bactericidal, meaning they actively kill bacteria rather than just stopping their growth (bacteriostatic).
A is incorrect as inhibiting DNA synthesis by targeting DNA gyrase is the mechanism of action of fluoroquinolones, not aminoglycosides.
B is incorrect as binding to the 50S ribosomal subunit and blocking peptide bond formation is the action of macrolides.
D is incorrect as inhibiting cell wall synthesis by blocking peptidoglycan cross-linking is the mechanism of β-lactam antibiotics (like penicillins).
E is incorrect as inhibiting mRNA transcription by binding to RNA polymerase is the action of rifampin, not aminoglycosides.
Question 23)
Answer: B) Binding to ergosterol, creating pores in the fungal membrane
Explanation: Amphotericin B is an antifungal drug. Fungal cell membranes contain ergosterol (a type of sterol that’s unique to fungi). This is analogous to cholesterol in human cells. Amphotericin B has a strong affinity for ergosterol and binds directly to it. After binding to ergosterol, amphotericin B molecules aggregate and form pores in the fungal cell membrane. These pores act like holes in the membrane, allowing ions like potassium (K+) and other small molecules to leak out of the fungal cell. The leakage of ions causes a disruption in the osmotic balance of the cell. This loss of ion regulation ultimately kills the fungal cell because the cell can no longer maintain the essential conditions needed for survival. In addition to creating pores, amphotericin B might also cause sterol sequestration. This means it binds to and traps ergosterol, which further weakens the membrane and its functionality.
A is incorrect as inhibition of ergosterol synthesis is the mechanism of azoles, not amphotericin B.
C is incorrect as Amphotericin B does not inhibit DNA synthesis or block thymidine kinase. This would be more relevant to nucleoside analogues or thymidine kinase inhibitors used in antiviral therapy not in antifungal therapy.
D is incorrect as disrupting protein synthesis by binding to the 30S subunit is the action of aminoglycosides used in antibiotics, not antifungals like amphotericin B.
E is incorrect as blocking fungal cell wall components is the action of echinocandins, which inhibit β-glucan synthesis.
Question 24)
Answer: E) It hides in immune-privileged sites like neurons and becomes latent.
Explanation: HSV (herpes simplex virus) evades the immune system by migrating to sensory ganglia (like the trigeminal ganglion) after primary infection. There, it enters a latent state where it stops replicating, making it nearly invisible to immune surveillance. Reactivation occurs during times of stress, illness, or fatigue, leading to recurrent symptoms like cold sores or genital ulcers.
A is incorrect as rapid mutation is characteristic of viruses like HIV, not HSV. HSV evades the immune system through latency, not constant antigenic changes.
B is incorrect as HSV does not form spores. Spores are more common in certain bacteria (like Clostridium species) and fungi (like Aspergillus)
C is incorrect as HIV integrates into the host genome, but HSV does not; it persists in neurons as a latent virus, not through genome integration.
D is incorrect as this mechanism is more typical of viruses like cytomegalovirus (CMV), which can block T cell activation through proteins like HLA decoy molecules.
Question 25)
Answer: D) They mimic natural nucleosides, getting incorporated into viral DNA, but prevent further elongation.
Explanation: NRTIs (such as zidovudine or tenofovir) mimic the structure of natural nucleosides. Once phosphorylated inside the cell, they are incorporated into the growing viral DNA by the enzyme reverse transcriptase. However, because these drugs lack the necessary 3′ hydroxyl group needed for DNA chain elongation, they act as chain terminators, stopping further DNA synthesis.
A is incorrect as integrase inhibitors (like raltegravir) prevent viral DNA integration into the host genome, but this is not the mechanism of NRTIs.
C is incorrect as fusion inhibitors (like enfuvirtide) prevent HIV from binding to CD4+ cells.
D is incorrect as protease inhibitors (like lopinavir or ritonavir) block HIV protease from cutting polypeptide chains into smaller pieces, but this is not the function of NRTIs.
E is incorrect as NRTIs do not bind to the RNA of the virus directly; they are incorporated into the viral DNA during the reverse transcription process.
Question 26)
Answer: A) It serves as a decoy to distract the immune system from recognizing infectious virions.
Explanation: HBsAg (Hepatitis B surface antigen) is produced in large quantities by HBV, often more than necessary for forming complete viral particles. Which are empty viral particles that don’t contain viral DNA. These non-infectious particles can overwhelm the host immune system, diverting attention away from the actual virus and promoting immune tolerance.
B is incorrect as ccDNA formed in hepatocytes allows the virus to persist in a latent state within the liver. This form of viral DNA is resistant to both the host’s immune response and current antiviral treatments, making it difficult to eradicate. This is why HBV can cause chronic infection and why the immune system often cannot fully clear the virus.
C is incorrect as HBeAg (hepatitis B e-antigen) is another viral protein that plays a crucial role in modulating the host’s immune response. It acts as a T cell tolerogen, downregulating the host’s immune defences by promoting immune tolerance, especially in the early phases of infection. This helps HBV persist without triggering a strong, immediate immune attack. It is HBeAg not HBsAg that is associated with immune modulation, promoting immune tolerance to HBV.
D is incorrect as HBV doesn’t directly block interferon production through HBsAg; immune evasion occurs more through antigen excess and immune tolerance.
E is incorrect as HBsAg is not a receptor-binding protein. Instead, HBV binds to the NTCP (sodium taurocholate co-transporting polypeptide) receptor on hepatocytes to enter the cell. This is a bile acid transporter and is highly expressed in liver cells, allowing the virus to specifically target and infect these cells.
Question 27:
Answer: B) Bacteroides
Explanation:
Bacteroides is considered the most common genus of bacteria in the human gastrointestinal tract. These anaerobic bacteria play a crucial role in the digestion of complex carbohydrates and contribute to maintaining gut health. Bacteroides species are abundant in the colon and are significant in breaking down dietary fibre and producing short-chain fatty acids, which are beneficial for gut health & metabolism.
Option A is incorrect because Bifidobacterium are beneficial bacteria commonly found in the gut but are not the most prevalent compared to other genera.
Option C is incorrect because Enterobacteriaceae, while present in the gut, are not as abundant as Bacteroides. Enterobacteriaceae include E.coli which are predominantly found in the UG tract & in smaller quantities in the GI tract. They are classified as gram negative bacteria that convert glycogen into lactic acid.
Option D is incorrect because Lactobacilli are important for gut health but typically occur in lower numbers than Bacteroides.
Option E is incorrect because Clostridium difficile is an obligate pathogenic bacterium associated with antibiotic-associated diarrhoea and colitis. The use of antibiotics reduces levels of competition in the GI tract, increasing survival & proliferation of C.difficile causing it to release toxins. Obligate pathogens always cause disease!

Question 28:
Answer: E) Plasmodium falciparum
Explanation: Plasmodium falciparum is the species of malaria parasite that causes the most severe symptoms and is responsible for the majority of malaria-related deaths worldwide. This species is known for its ability to rapidly multiply in the bloodstream and can cause severe complications, including cerebral malaria, severe anaemia, and respiratory distress.
Option A is incorrect because Plasmodium malariae is associated with a milder form of malaria, typically causing chronic infection with fewer complications compared to P. falciparum.
Option B is incorrect because Plasmodium knowlesi, which primarily infects monkeys, can cause severe malaria, but it is less prevalent in humans compared to P. falciparum and is not the most severe overall.
Option C is incorrect because Plasmodium vivax can cause relapsing malaria due to its dormant liver stages but generally leads to milder symptoms than P. falciparum.
Option D is incorrect because Plasmodium ovale also causes a milder form of malaria, similar to P. vivax, and is not associated with the severe complications seen with P. falciparum.

Question 29:
Answer: A) Streptococcus pneumoniae
Explanation: Streptococcus pneumoniae is the most common bacterial cause of meningitis, especially in adults and young children. This bacterium can lead to pneumococcal meningitis, which is a severe infection of the membranes surrounding the brain and spinal cord. S. pneumoniae is particularly dangerous because it can cause rapid, severe inflammation and has a high risk of complications.
Option B is incorrect because Haemophilus influenzae, though once a leading cause of bacterial meningitis in children, has been largely controlled in many regions through vaccination (Hib vaccine). It is now a less common cause compared to S. pneumoniae.
Option C is incorrect because Neisseria meningitidis is a significant cause of bacterial meningitis, especially in young adults and in settings like dormitories. While it is a common cause, it is less frequent than S. pneumoniae.
Option D is incorrect because Staphylococcus aureus rarely causes meningitis; it is more commonly associated with skin infections, respiratory infections, and endocarditis.
Option E is incorrect because Pseudomonas aeruginosa, although a serious pathogen in hospital settings, is not a common cause of community-acquired bacterial meningitis. It more frequently causes infections in individuals with weakened immune systems or those with chronic health conditions.

Question 30:
Answer: A) Norovirus
Explanation: Norovirus currently does not have a vaccine available. Despite being a common & very contagious cause of gastroenteritis, no effective vaccine has been developed and approved for public use. Preventive measures rely on hygiene practices and sanitisation to reduce transmission. Treatment typically focuses on managing symptoms, such as staying hydrated, but no antiviral therapy exists to specifically target norovirus either.
Option B is incorrect because a highly effective vaccine is available for measles, usually given as part of the MMR (measles, mumps, rubella) vaccine. Measles can also be prevented and treated with supportive care, and severe cases can be managed with treatments like vitamin A supplementation to reduce symptoms.
Option C is incorrect because multiple COVID-19 vaccines are available globally, including mRNA vaccines like Pfizer-BioNTech and Moderna, as well as vector-based and inactivated vaccines. COVID-19 has several treatment options, including antiviral medications such as remdesivir.
Option D is incorrect because pertussis (whooping cough) has a vaccine, which is commonly administered in combination with vaccines for diphtheria and tetanus (DTaP). It can also be treated via antibiotics if a person contracts pertussis.
Option E is incorrect because tuberculosis has a vaccine, known as the Bacille Calmette-Guérin (BCG) vaccine, which is primarily used in countries with high TB prevalence and is effective in preventing severe forms of tuberculosis in children. Tuberculosis has multiple treatment options, including antibiotics like isoniazid and rifampin, typically administered over several months as part of combination therapy.
Question 31:
Answer: A) Measles
Explanation: Ribavirin is an antiviral medication used in some cases for severe measles infections, especially in immunocompromised patients, though it is not a standard treatment for measles in all cases. Ribavirin is also used to treat a variety of other viral infections.
Option B is incorrect because HIV is primarily treated with antiretroviral therapy (ART) such as thymidine kinase inhibitors, reverse transcriptase inhibitors, nucleoside analogues, protease inhibitors & integrase inhibitors.
Option C is incorrect because COVID-19 is typically treated with different antiviral agents, such as remdesivir, and supportive care.
Option D is incorrect because hepatitis B is commonly treated with antiviral medications like entecavir and tenofovir.
Option E is incorrect because herpes simplex virus (HSV) infections are usually treated with antiviral medications like acyclovir, valacyclovir, and famciclovir.
Question 32:
Answer: C) Macrolides
Explanation: Macrolides, such as erythromycin, act on the P site of the 50S ribosomal subunit in bacteria. By binding to this site, macrolides prevent the translocation of the growing polypeptide chain, effectively blocking its exit and thereby halting protein synthesis. This action makes macrolides effective in treating bacterial infections by stopping bacterial protein production.
Option A is incorrect because tetracyclines target the 30S ribosomal subunit, not the 50S, and inhibit protein synthesis by preventing the attachment of tRNA to the ribosome.
Option B is incorrect because aminoglycosides also bind to the 30S subunit, interfering with protein synthesis by causing misreading of the mRNA and resulting in defective proteins.
Option D is incorrect because β-lactams do not target the ribosome. They work by inhibiting bacterial cell wall synthesis through binding to penicillin-binding proteins, which interferes with cell wall formation.
Option E is incorrect because glycopeptides are not a class of antibiotics that act on ribosomes. Instead, glycopeptides (e.g., vancomycin) work by inhibiting bacterial cell wall synthesis. They bind to D-alanine specifically, preventing it from binding to L-lysine thus disrupting the peptidoglycan layer.

Question 33:
Answer: C) Giardia lamblia
Explanation: Giardia lamblia is a protozoan parasite classified under the phylum Metamonad, which is characterised by its unique flagella and lack of mitochondria. This parasite is well-known for causing giardiasis, a common intestinal infection in humans. Giardia has a distinctive trophozoite form with a flagellated, teardrop shape, allowing it to move and adhere to the lining of the small intestine.
Option A is incorrect because Cryptosporidium is an apicomplexan protozoan, not a metamonad. It causes cryptosporidiosis, primarily affecting the intestines similar to giardia lamblia & is also transmitted via the orofecal route.
Option B is incorrect because Toxoplasma gondii is also an apicomplexan protozoan, not a metamonad. It is known for causing toxoplasmosis, which can have severe effects in immunocompromised individuals and during pregnancy. Toxoplasma is mainly transmitted via cat faeces (litter boxes) or via contaminated food or water.
Option D is incorrect because Taenia solium is a type of tapeworm (cestode) and not a protozoan at all. It causes taeniasis and can lead to cysticercosis when larvae infect tissues. Taeniasis can cause horrific systemic problems including encephalopathy if larvae invade the brain & muscle wasting.
Option E is incorrect because Entamoeba histolytica is an amoebozoan protozoan, not a metamonad. It causes amoebiasis, which can lead to severe intestinal and extraintestinal infections.

Question 34:
Answer: A) They target the glucan synthase enzyme (Fks1p) that is unique to fungal cell walls. This interrupts the ß1,3 linkage between glucan molecules.
Explanation: Echinocandins are a class of antifungal agents that inhibit the synthesis of β-(1,3)-D-glucan, an essential component of the fungal cell wall. By targeting the glucan synthase enzyme (Fks1p), echinocandins disrupt the integrity of the fungal cell wall, leading to the formation of cell pores, thus cell lysis and death. This mechanism is specific to fungi, making echinocandins effective against various fungal infections, particularly those caused by Candida and Aspergillus species.
Option B is incorrect because it describes the action of azole antifungals, which inhibit lanosterol 14-alpha demethylase, affecting ergosterol synthesis in fungal cell membranes not cell WALLS!
Option C is incorrect as it refers to protease inhibitors, which are not the mechanism of action for echinocandins. Instead, these are used as antiviral medications.
Option D is incorrect because it describes the action of beta-lactam antibiotics that inhibit transpeptidase enzymes, preventing peptidoglycan cross-linking in bacterial cell walls.
Option E is incorrect since as this is referring to sulphonamide antibiotics that inhibit the synthesis of dihydropteroate synthase, affecting folate metabolism in bacteria.

Question 35:
Answer: B) Helminth – nematode
Explanation: Strongyloides stercoralis is a parasitic nematode, commonly known as the threadworm. It belongs to the class of helminths, specifically the nematodes, which are characterised by their elongated, cylindrical bodies. S. stercoralis is notable for its ability to cause strongyloidiasis, a disease that can range from asymptomatic to severe in immunocompromised individuals often due to walking bare-foot on contaminated soil.
Option A is incorrect because trematodes are flatworms (flukes), which have a different morphology and life cycle compared to nematodes.
Option C is incorrect as cestodes are also flatworms (tapeworms), characterised by their segmented bodies, and are distinct from nematodes.
Option D is incorrect because apicomplexans are a group of protozoan parasites, including Plasmodium and Toxoplasma, which have different biological characteristics compared to nematodes.
Option E is incorrect since metamonads are also protozoans, including Giardia lamblia and Entamoeba histolytica, which do not share the characteristics of nematodes like S. stercoralis.

Question 36:
Answer: C) Schistosoma aka swimming with snails
Explanation: Katayama fever is associated with infection by the Schistosoma species, particularly Schistosoma mansoni and Schistosoma japonicum. This condition occurs during the acute phase of schistosomiasis transmitted via snails, characterised by symptoms such as fever, malaise, myalgia, and eosinophilia, as the body reacts to the migrating schistosome larvae and their eggs.
Option A is incorrect because Strongyloides stercoralis causes strongyloidiasis, which presents with a rash, dry cough, diarrhoea, bloating & abdominal pain. In severe cases, it can cause a disseminated infection in immunocompromised individuals causing death in extreme cases.
Option B is incorrect as Giardia lamblia is known for causing giardiasis, which typically presents with gastrointestinal symptoms such as diarrhoea, abdominal pain, cramps, weight loss, IBS & lactose intolerance rather than fever.
Option D is incorrect because Toxoplasma gondii causes toxoplasmosis, which can lead to a variety of symptoms, ranging from mild to deadly such as diarrhoea & abdominal pain to seizures & strokes.
Option E is incorrect since Cryptosporidium causes cryptosporidiosis, primarily leading to gastrointestinal symptoms like diarrhoea, without the characteristic fever associated with schistosomiasis.

Question 37:
Answer: A) Dermatophytes
Explanation: Dermatophytes are a group of fungi that specifically require keratin, a protein found in hair, skin, and nails, for their growth and survival. They are responsible for various skin infections known as tinea, commonly referred to as ringworm. Dermatophytes thrive on keratinised tissues, which is why they are often associated with superficial fungal infections.
Option B is incorrect because tinea corporis refers to a specific fungal infection caused by dermatophytes but does not represent a type of fungus itself.
Option C is incorrect as mycetoma (also known as “Madura foot”) is a chronic fungal infection caused by certain fungi and bacteria, but it does not specifically require keratin for growth.
Option D is incorrect because Candida is a yeast that can grow on a variety of substrates, but it does not specifically require keratin.
Option E is incorrect because Cryptococcus neoformans is a yeast that primarily grows on bird droppings and in decaying organic matter, rather than requiring keratin for its growth.

Question 38:
Answer: B) Pertussis
Explanation: The whole-cell pertussis vaccine contains killed (inactivated) Bordetella pertussis bacteria. This type of vaccine elicits an immune response without causing disease, providing immunity against whooping cough. Whole-cell pertussis vaccines are effective but can cause more side effects than newer acellular pertussis vaccines, which contain purified components of the bacterium. Thus, acellular vaccines have been utilised on pregnant women to provide immunity to the foetus however their effectiveness is lower (lower immunity) than the whole cell vaccine.
Option A is incorrect because pneumococcal and meningococcal vaccines generally use polysaccharide or conjugate forms rather than whole-cell inactivated bacteria.
Option C is incorrect as the tetanus vaccine is a toxoid vaccine, made from inactivated tetanus toxins.
Option D is incorrect because the hepatitis B vaccine is a recombinant vaccine that uses a surface antigen protein rather than the whole virus.
Option E is incorrect as the diphtheria vaccine is also a toxoid vaccine, using an inactivated form of the diphtheria toxin.


Question 39:
Answer: C) Diagnosed via acid-fast staining
Explanation: Cryptosporidiosis, caused by the parasite Cryptosporidium, is uniquely diagnosed through acid-fast staining, which allows the detection of its oocysts in stool samples. Cryptosporidium oocysts are acid-fast, meaning they retain the stain even after treatment with an acid decolouriser, distinguishing them from other parasites commonly identified with different techniques.
Option A is incorrect because trichrome staining is typically used for diagnosing other protozoan infections, such as Entamoeba histolytica & Giardia lamblia.
Option B is incorrect as serology is mainly used in the diagnosis of Toxoplasmosis & Schistosoma.
Option D is incorrect since immunoassays, while sometimes used, are not unique to Cryptosporidiumdiagnosis & are not the main method in diagnosing cryptosporidium.
Option E is incorrect because PCR is used for various pathogens such as toxoplasmosis but does not provide a unique diagnostic method for Cryptosporidium compared to acid-fast staining.

Question 40:
Answer: E) Mycetoma
Explanation: Mycetoma is an example of a subcutaneous fungal infection that typically involves the skin, subcutaneous tissues, and sometimes bones. It usually occurs following traumatic implantation of the fungus through the skin, often in tropical and subtropical regions. Mycetoma can be caused by both fungal (eumycetoma) and bacterial (actinomycetoma) pathogens.
Option A is incorrect because although mucormycosis is a fungal pathogen, it primarily is a systemic infection affecting immunocompromised individuals, often invading nasal passages, sinuses, and lungs. Mucormycosis may lead to rhinocerebral & frontal lobe abscesses in severe cases.
Option B is incorrect as Histoplasma causes histoplasmosis, a systemic fungal infection typically affecting the lungs and spreading to other organs in severe cases. It is spread by bat droppings commonly in caves.
Option C is incorrect because Candida generally causes mucocutaneous or systemic infections, especially in immunocompromised individuals, rather than subcutaneous infections. Candida is also a yeast infection, not a fungal!
Option D is incorrect as Aspergillus primarily causes respiratory infections, such as aspergillosis, and can disseminate in immunocompromised patients but is not typically associated with subcutaneous infections.


Question 41:
Answer: A) Cryptosporidiosis
Explanation: Cryptosporidium, the parasite responsible for cryptosporidiosis, is an apicomplexan that is commonly transmitted via contaminated water and food, especially while travelling in areas with poor sanitation. The infection is known for causing watery diarrhoea and can be particularly severe in immunocompromised individuals.
Option B is incorrect because Giardia lamblia is a flagellated protozoan, specifically a metamonad, not an apicomplexan, though it is also transmitted via contaminated water and food.
Option C is incorrect as Toxoplasma gondii, though an apicomplexan, is primarily transmitted through undercooked meat, cat faeces, or congenitally, rather than primarily via water and food.
Option D is incorrect because Taenia solium is a cestode (tapeworm) and is usually transmitted through undercooked pork, not water.
Option E is incorrect because Strongyloides stercoralis is a nematode transmitted through skin contact with contaminated soil, not by ingestion of contaminated food or water.

Question 42:
Answer: E) Amphotericin B
Explanation: Amphotericin B is an antifungal medication, not typically used in the treatment of bacterial infections. It works by binding to ergosterol in fungal cell membranes, leading to cell membrane disruption. Because bacteria do not contain ergosterol, Amphotericin B is ineffective against them.
Option A is incorrect because aminoglycosides are antibiotics used to treat various bacterial infections by inhibiting protein synthesis. They bind to the 30S ribosomal subunit, causing tRNA misreading and, consequently, misfolding of the polypeptide chain.
Option B is incorrect as β-lactams (e.g., penicillins, cephalosporins) are a widely used class of antibiotics that inhibit bacterial cell wall synthesis. β-lactams target transpeptidase, the enzyme responsible for cross-linking peptidoglycan chains in bacterial cell walls
Option C is incorrect since tetracyclines are antibiotics that inhibit protein synthesis in bacteria by targeting the ribosome, preventing tRNA attachment.
Option D is incorrect because macrolides are antibiotics that inhibit bacterial protein synthesis by binding to the 50S ribosomal subunit.

Question 43:
Answer: A) Taenia solium
Explanation: Taenia solium, also known as the pork tapeworm, can cause a condition called neurocysticercosis when its larvae invade the central nervous system. This condition can lead to seizures, strokes, radiculopathy, and even fatality if left untreated. Neurocysticercosis occurs when a person ingests the eggs of Taenia solium, which then hatch and migrate to tissues, including the brain, where they form cysts.
Option B is incorrect because Toxoplasma gondii, though it can infect the brain and cause issues in immunocompromised individuals, is a protozoan, not a helminth.
Option C is incorrect as Schistosoma is a blood fluke that primarily affects the liver, intestines, and bladder, rather than the brain.
Option D is incorrect because Giardia lamblia is a protozoan parasite that affects the intestines, causing gastrointestinal symptoms, not neurological issues.
Option E is incorrect since Cryptosporidium is also a protozoan parasite that causes intestinal infections, not brain infections.

Question 44:
Answer: C) Varicella Zoster Virus
Explanation: The “dew drops on a rose petal” appearance in a dermatomal distribution is characteristic of Varicella Zoster Virus (VZV) reactivation, which causes shingles (herpes zoster). This description refers to the appearance of fluid-filled vesicles on a red base, which often follow a nerve distribution on one side of the body. Varicella Zoster Virus is also responsible for chickenpox, where a similar vesicular rash appears but is more generalised rather than dermatomal.
Option A is incorrect because Herpes Simplex Virus type 1 (HSV-1) typically causes cold sores around the mouth & face.
Option B is incorrect as Herpes Simplex Virus type 2 (HSV-2) usually causes genital lesions, which also do not follow a dermatomal pattern.
Option D is incorrect because Epstein Barr Virus (EBV) is primarily associated with infectious mononucleosis which cause systemic effects.
Option E is incorrect as Cytomegalovirus (CMV) usually causes systemic infections, especially in immunocompromised patients, but does not produce a vesicular dermatomal rash.

Question 45:
Answer: C) Mucormycosis
Explanation: Mucormycosis, also known as zygomycosis, is a serious fungal infection commonly caused by fungi in the order Mucorales, such as Rhizopus and Mucor species. It is a feared complication in patients with diabetic ketoacidosis (DKA) because the acidic environment and elevated blood glucose levels provide an ideal environment for these fungi to grow and invade tissues. Mucormycosis can manifest as two main types: rhinocerebral (fronto-orbital) mucormycosis, which often begins in the sinuses and may spread to the brain, and pulmonary mucormycosis, which affects the lungs.
Option A is incorrect because Aspergillus species cause aspergillosis, which typically affects the lungs and is more common in immunocompromised patients rather than specifically in DKA patients.
Option B is incorrect as mycetoma is a chronic subcutaneous infection that causes skin lesions, not associated with diabetic ketoacidosis.
Option D is incorrect because Candida infections are common in diabetes but are not as aggressive as mucormycosis in the setting of DKA.
Option E is incorrect as Cryptococcus primarily causes meningitis, especially in immunocompromised individuals, and is not specifically linked to DKA.

Question 46:
Answer: A) Taenia solium
Explanation: Taenia solium is a tapeworm, specifically a cestode infection caused by consuming undercooked or contaminated pork. This parasite can lead to two types of infections: taeniasis, where the adult tapeworm lives in the intestine, and cysticercosis, where the larvae invade tissues, including the brain, potentially causing neurocysticercosis.
Option B is incorrect because Tinea capitis is a fungal infection (ringworm) of the scalp, not a helminth or tapeworm infection. It is caused by dermatophytes which degrade keratin.
Option C is incorrect as “Tinea giardia” is not a valid term; Giardia is a protozoan that causes giardiasis, a gastrointestinal infection, but is unrelated to tinea or tapeworms.
Option D is incorrect as toxoplasmosis is caused by the protozoan Toxoplasma gondii, typically transmitted through cat faeces or undercooked meat, but not specifically pork or tapeworm-related.
Option E is incorrect because Taenia coli is not a parasite; rather, it is a feature of the large intestine’s anatomy (longitudinal muscle bands) and is unrelated to any tapeworm or infection.
Question 47:
Answer: D) Trimethoprim
Explanation: Trimethoprim is a medication that inhibits the enzyme dihydrofolate reductase, which is responsible for converting dihydrofolate to tetrahydrofolate in folate metabolism. This action disrupts bacterial DNA synthesis by reducing the availability of tetrahydrofolate, an essential cofactor for nucleotide production (specifically purines & thymidine). While Trimethoprim blocks this pathway in bacteria, humans also have dihydrofolate reductase, but Trimethoprim selectively targets the bacterial enzyme more effectively. Use of trimethoprim during pregnancy is generally not recommended since it can cause neural tube defects in the developing foetus.
Option A is incorrect because sulphonamides inhibit dihydropteroate synthase, an earlier enzyme in the folate synthesis pathway, but they do not directly convert dihydrofolate to tetrahydrofolate.
Option B is incorrect as ß-lactams work by inhibiting bacterial cell wall synthesis, not folate metabolism.
Option C is incorrect because penicillin, a type of ß-lactam antibiotic, also targets cell wall synthesis, not folate metabolism.
Option E is incorrect as acyclovir is an antiviral medication that inhibits viral DNA polymerase, used primarily for herpesvirus infections, and is unrelated to folate metabolism.

Question 48:
Answer: D) Alum
Explanation: Alum (aluminium salts, such as aluminium hydroxide, aluminium phosphate, or potassium aluminium sulphate) is the most common adjuvant used in vaccines. It enhances the immune response by stimulating antigen-presenting cells (via the innate immune system), thereby improving the vaccine’s effectiveness & stimulating T lymphocyte response. Alum has been widely used as an adjuvant in vaccines for many years due to its safety and efficacy profile.
Option A & E are incorrect since neither magnesium nor potassium are used as adjuvants in vaccines.
Option B is incorrect as argon is an inert gas and has no role as a vaccine adjuvant.
Option C is incorrect because, while phosphate may be present in some vaccine formulations as a buffer, it is not used as an adjuvant to enhance immune response.

Question 49:
Answer: E) Thrombin
Explanation: Thrombin is not released by mast cells during degranulation. Thrombin is primarily involved in the blood coagulation pathway, where it converts fibrinogen to fibrin to form blood clots. It is produced by the liver and circulates in the blood, playing a role in haemostasis rather than in the allergic or inflammatory responses mediated by mast cells.
Option A is incorrect because heparin, an anticoagulant, is released by mast cells during degranulation and helps prevent blood clotting in affected tissues.
Option B is incorrect because histamine is a key mediator released by mast cells that causes vasodilation, increased vascular permeability, and contributes to allergic reactions and inflammation.
Option C is incorrect because chymase, a protease, is also released by mast cells and contributes to tissue remodelling and inflammation.
Option D is incorrect because tryptase, another protease, is released by mast cells. Tryptase has numerous functions including degrading IgE crosslinks & allergens, amplifying the effect of histamine, increasing heart rate & smooth muscle contractility, generating C3a & bradykinin to activate the complement system & plays a role in airway remodelling by through stimulation of collagen & fibroblast proliferation. Tryptase is a key biomarker of mast cell degranulation & is raised in blood tests following allergies.


Question 50:
Answer: B) IL-4
Explanation: IL-4 is a crucial cytokine secreted by T helper cells that plays a significant role in the immune response, particularly during type 1 hypersensitivity reactions. It triggers B cells to undergo class switching, leading to the production of IgE antibodies. This class switching is essential for the allergic response, as IgE binds to allergens and mediates the activation of mast cells and basophils, resulting in the characteristic symptoms of allergies.
Option A is incorrect because IL-2 primarily promotes the growth and proliferation of T cells, rather than directly influencing B cell class switching to IgE.
Option C is incorrect as IL-6 is involved in the inflammatory response and can stimulate B cell differentiation, but it is not specifically responsible for inducing class switching to IgE.
Option D is incorrect because IL-8 primarily acts as a chemokine that attracts neutrophils to sites of infection or inflammation.
Option E is incorrect because IL-10 is an anti-inflammatory cytokine that helps regulate immune responses but does not specifically induce class switching to IgE.

Question 51:
Answer: E) Streptococcus pyogenes
Explanation: Streptococcus pyogenes, also known as Group A Streptococcus, produces superantigens, particularly streptococcal pyrogenic exotoxins (SPEs), namely SpeA & SpeC. These superantigens can trigger a strong immune response by activating a large number of T cells, leading to conditions such as scarlet fever and toxic shock-like syndrome.
Option A is also correct because Staphylococcus aureus is known for its superantigen production, but since the question emphasises “gram-positive bacterial chains,” Streptococcus pyogenes, which forms chains, fits the criteria more specifically. Staphylococcus aureus form bacterial ‘clusters’ not chains.
Option B is incorrect as coagulase-negative staphylococci do not produce superantigens.
Option C is incorrect since Streptococcus pneumoniae is not known for producing superantigens but does produce pneumoniases & autolysins.
Option D is incorrect because Streptococcus viridians does not produce superantigens and is primarily associated with dental infections and endocarditis.
Question 52:
Answer: B) Type II
Explanation: Type II hypersensitivity, also known as immune-mediated cytotoxic hypersensitivity, involves the binding of antibodies (typically IgG or IgM) to antigens on the surface of cells, organs & tissue, leading to their destruction. This can occur through mechanisms such as complement activation, opsonisation, or antibody-dependent cellular cytotoxicity (ADCC). Conditions such as autoimmune haemolytic anaemia and haemolytic disease of the new-born are examples of Type II hypersensitivity reactions.
Option A (Type I) refers to immediate hypersensitivity reactions mediated by IgE, such as allergies and anaphylaxis.
Option C (Type III) involves immune complex-mediated hypersensitivity, where antibodies bind to soluble antigens that disseminate in the blood, later forming complexes that deposit in tissues and provoke inflammation.
Option D (Type IV) is delayed-type hypersensitivity mediated by T cells, such as in contact dermatitis or graft-versus-host disease.
Option E (Type V) is immune mediated hypersensitivity, however the difference between type II & type V is that type II involves destruction of tissue whereas type V involves up/downregulation of receptor and generally refers to diseases where antibodies stimulate receptor activity.

Question 53:
Answer: D) Type V
Explanation: Graves’ disease is classified as a Type V hypersensitivity reaction. In this condition, antibodies known as thyroid-stimulating immunoglobulins (TSIs) bind to the thyroid-stimulating hormone (TSH) receptor on thyroid cells. This binding stimulates the thyroid gland to produce excess thyroid hormones, leading to hyperthyroidism. Unlike traditional Type II hypersensitivity, which involves antibody-mediated cell destruction, Type V hypersensitivity involves the stimulation of normal cellular function through receptor activation.
Option A is incorrect because Type II typically refers to cytotoxic hypersensitivity where antibodies lead to cell destruction rather than stimulation.
Option B is incorrect as Type III involves immune complexes causing inflammation and tissue damage by disseminating into the blood.
Option C is incorrect because Type IV is a delayed hypersensitivity reaction mediated by T cells and is not relevant here.
Option E is incorrect because Type VI it involves both B & T cell response.

Question 54:
Answer: D) Pseudomonas aeruginosa
Explanation: Pseudomonas aeruginosa is a gram-negative bacterium known for secreting blue-green pigments, specifically pyocyanin and pyoverdine. These pigments contribute to its characteristic colour and are also associated with its pathogenicity and ability to thrive in various environments, including hospital settings.
Option A is incorrect because Neisseria gonorrhoeae is a gram-negative bacterium but does not produce blue-green pigments.
Option B is incorrect as Streptococcus pyogenes is a gram-positive bacterium and does not produce blue-green pigments.
Option C is incorrect because coagulase-positive staphylococcus, such as Staphylococcus aureus, is a gram-positive bacterium and does not secrete blue-green pigments.
Option E is incorrect since while some members of Enterobacteriaceae are gram-negative, they do not typically produce blue-green pigments associated with Pseudomonas aeruginosa.

Question 55:
Answer: A) Cytomegalovirus
Explanation: Cytomegalovirus (CMV) is a member of the herpesvirus family and is known to cause pneumonia in immunocompromised patients, including those with HIV/AIDS. CMV pneumonia is especially problematic in patients with advanced HIV disease and low CD4 counts, often requiring antiviral treatment due to the severe complications it can cause in these individuals.
Option B is incorrect because Streptococcus pneumoniae, while a common cause of bacterial pneumonia, is not a herpesvirus.
Option C is incorrect as Pneumocystis jirovecii, a fungus, also causes pneumonia in HIV patients but is unrelated to the herpesvirus family. It is one of the main causes of severe pneumonia in HIV patients.
Option D is incorrect because invasive aspergillosis is caused by Aspergillus species, which are moulds.
Option E is incorrect as invasive candidiasis is caused by Candida species, which are fungi, and does not belong to the herpesvirus family.

Question 56:
Answer: B) Specific pharmacologic immune modulators
Explanation: Specific pharmacologic immune modulators, particularly calcineurin inhibitors like cyclosporine and tacrolimus, work by blocking the production of interleukin-2 (IL-2), a crucial cytokine needed for T cell activation and proliferation. By inhibiting IL-2 production, these drugs prevent T cell proliferation, thereby leading to immunosuppression. This mechanism is commonly used to prevent rejection in organ transplants and to treat autoimmune diseases.
Option A is incorrect because steroids suppress immune function broadly by reducing inflammation and cytokine production. They do this by killing lymphocytes & prevent neutrophils from leaving the blood and entering tissues.
Option C is incorrect as cytotoxic agents inhibit cell division across various cell types, affecting both T cells and other rapidly dividing cells, but they do not specifically block IL-2 production.
Option D is incorrect because bone marrow transplants do not directly inhibit IL-2 production; instead, they aim to replace damaged or dysfunctional immune systems.
Option E is incorrect because biologics target specific immune pathways e.g. anti TNA-α molecule (TNA-α is an inflammatory cytokine) so blocks inflammation. They can also include killing antibodies whilst others prevent activation of macrophages.
Question 57:
Answer: E) Histoplasma
Explanation: Histoplasma capsulatum is a dimorphic fungus, which means it has two distinct forms depending on the temperature. In the environment, especially in soil with bird or bat droppings, it exists as a mould. However, when it infects a human host at body temperature, it transforms into a yeast form. This ability to switch between forms is characteristic of dimorphic fungi and aids in their pathogenicity.
Option A is incorrect because Mucormycosis is caused by fungi in the Mucorales order, which grow as moulds and do not exhibit dimorphism.
Option B, Cryptococcus neoformans, is incorrect because this fungus is a yeast and does not display dimorphism; it remains in a yeast form at all temperatures.
Option C, Dermatophyte, is incorrect as dermatophytes are moulds that infect keratinised tissues like skin, hair, and nails, and do not show dimorphic behaviour.
Option D, Candida, is incorrect because Candida species are generally yeasts. Although they can form pseudohyphae or true hyphae under certain conditions, they are not classified as dimorphic.

Question 58:
Correct Answer: A) Activation of tissue factor causes localized clotting, leading to reduced clotting factors concentration in blood and secondary bleeding (disseminated intravascular coagulation)
Correct: In sepsis, widespread inflammation can activate tissue factor, triggering the coagulation cascade and leading to widespread clotting within small vessels (disseminated intravascular coagulation or DIC). As clotting factors and platelets are consumed, the patient develops a bleeding tendency due to depletion of clotting reserves, leading to prolonged PT, PTT, and low fibrinogen levels.
Explanation:
B) Excessive inflammatory cytokines inhibit thrombin generation, preventing clot formation and leading to primary bleeding tendency
- Incorrect: While inflammatory cytokines play a role in modulating coagulation during sepsis, they do not directly prevent thrombin generation in a way that would solely cause a primary bleeding tendency. In sepsis, initial hypercoagulability often precedes consumption of clotting factors and subsequent bleeding.
C) Sepsis results in a decrease in endothelial production of von Willebrand factor (vWF), preventing adequate platelet adhesion and aggregation
- Incorrect: Sepsis does not primarily cause a decrease in vWF production. In fact, endothelial cells may release more vWF during sepsis as part of the inflammatory response. The bleeding observed is more related to consumption of clotting factors in disseminated intravascular coagulation (DIC) rather than isolated vWF issues.
D) Pro-inflammatory cytokines suppress the synthesis of clotting factors in the liver, leading to systemic bleeding without clot formation
- Incorrect: While cytokines may affect liver function in severe sepsis, the bleeding tendency observed is due more to consumption coagulopathy (DIC) rather than suppression of clotting factor production. The initial response in sepsis often involves clot formation, followed by factor depletion.
E) Sepsis leads to an overproduction of plasminogen activator inhibitor-1 (PAI-1), causing hyperfibrinolysis and a direct reduction in fibrin clot stability
- Incorrect: While PAI-1 plays a role in the regulation of fibrinolysis, sepsis typically triggers clotting pathways more than fibrinolytic pathways initially. Hyperfibrinolysis may contribute, but the primary mechanism for clotting factor depletion and bleeding in sepsis is related to DIC and widespread consumption of coagulation components.
Question 59:
Correct Answer: D) Loss of vascular smooth muscle tone due to excessive production of nitric oxide, leading to systemic vasodilation
Correct: Septic shock is primarily characterized by a massive release of inflammatory mediators and cytokines in response to infection, leading to excessive production of nitric oxide and other vasodilatory substances. This causes loss of vascular smooth muscle tone, leading to systemic vasodilation and a drop in blood pressure despite adequate blood volume.
Explanation:
A) Increased capillary permeability leading to massive fluid loss from the intravascular space into tissues, causing relative hypovolemia
- Partially correct but not the best explanation: Increased capillary permeability does occur in septic shock, leading to fluid shift into tissues and relative hypovolemia. However, the primary mechanism of hypotension is widespread vasodilation due to inflammatory mediators, making systemic vasodilation the best answer.
B) Direct bacterial invasion of the myocardium, causing acute heart failure and a drop in cardiac output
- Incorrect: While some infections can involve the heart (e.g., endocarditis), septic shock typically results from systemic vasodilation and not direct myocardial invasion. Myocardial depression may occur later in septic shock, but it is not the primary cause of hypotension.
C) Dehydration due to fever-induced sweating and vomiting, causing hypovolemia and secondary hypotension
- Incorrect: Although dehydration can exacerbate hypotension in sepsis, septic shock is driven primarily by vasodilation and changes in vascular permeability rather than just fluid loss from fever and vomiting.
E) Suppression of the adrenal glands by bacterial endotoxins, leading to insufficient cortisol production and vascular collapse
- Incorrect: While adrenal insufficiency (e.g., relative adrenal insufficiency or adrenal crisis) can occur in severe sepsis and exacerbate shock, it is not the primary mechanism driving hypotension in septic shock. Vasodilation and capillary permeability changes are the primary drivers of hypotension.
Question 60:
Correct Answer: D) Initiating intravenous fluid resuscitation with crystalloids
Correct: Fluid resuscitation is crucial in sepsis management to restore intravascular volume, increase blood pressure, and improve perfusion. This intervention directly helps stabilize the patient’s circulation by addressing hypotension and potential hypoperfusion due to sepsis-induced vasodilation and capillary leakage.
Explanation:
Sepsis 6
Sepsis 6- is a method to both treat and measure sepsis and septic shock at the same time, it has 3 therapeutic criteria and 3 diagnostic criteria which are the following:
3 Diagnostic Measures
- Take blood cultures and consider source control
- Measure serial serum lactates: (lactate <1 = normal, Lactate>2 =septic shock)
- Measure urine output
3 Therapeutic Measures
- Keep oxygen saturation of 94%
- Administer antibiotics
- Administer intravenous fluid
A) Administering broad-spectrum antibiotics immediately
- Incorrect: Although this is a crucial step in the therapeutic measure of Sepsis 6 to control the source of infection, it does not directly stabilize circulation. Antibiotics aim to control the underlying infection but do not immediately correct hypotension.
B) Delivering high-flow oxygen to maintain oxygen saturation
- Incorrect:whilst this is also a therapeutic criteria of sepsis 6, High-flow oxygen helps improve oxygen delivery to tissues, which is essential in sepsis management. However, it does not directly address circulatory collapse or hypotension. This is a supportive measure rather than a circulatory intervention.
C) Obtaining blood cultures prior to antibiotic administration
- Incorrect: Blood cultures are essential to identify the causative organism and guide antibiotic therapy. While they are a part of the diagnostic criteria of Sepsis 6, they do not stabilize circulation directly.
E) Measuring serum lactate and repeating the measurement if elevated
- Incorrect: Measuring serum lactate is important for assessing tissue hypoperfusion and guiding treatment; it provides an indicator of the severity of sepsis and the response to treatment but does not directly stabilize the patient’s circulation.
Question 61:
Correct Answer: C) Regular contraction of the detrusor muscle leads to frequent flushing of pathogens from the bladder
Correct: The bladder’s normal function includes periodic emptying, which helps to mechanically flush out bacteria, reducing their ability to adhere to the bladder wall and establish infection. This flushing action is a critical defense mechanism against urinary tract infections (UTIs).
Explanation:
A) The presence of a thick mucosal layer lining the bladder prevents adherence of bacteria to the bladder wall
- Incorrect: The bladder does have a mucosal lining, but it is not thick enough to solely prevent bacterial adherence. Other factors, such as urine flow, play a more direct role in maintaining sterility.
B) The acidic pH of urine inhibits bacterial growth within the bladder
- Incorrect: While urine can sometimes be acidic, its pH can vary, and this alone is not enough to maintain sterility in the bladder. Many pathogens, including common uropathogens like E. coli, can tolerate or adapt to a wide range of pH levels.
D) A protective layer of immunoglobulin A (IgA) coats the bladder surface, neutralising potential pathogens in the urine
- Incorrect: While IgA does contribute to mucosal immunity and is present in other areas such as the gastrointestinal and respiratory tracts, its role in the urinary bladder is less pronounced than other mechanical defences like urine flow and flushing.
E) The unidirectional flow of urine from the kidneys to the urethra prevents retrograde migration of pathogens
- Incorrect: Unidirectional flow is important in preventing kidney infections (pyelonephritis) due to retrograde spread, but it does not alone explain why the bladder remains sterile. The periodic expulsion of urine and the bladder’s self-flushing properties are more directly responsible for maintaining sterility.
Question 62:
Correct Answer: B) Broad-spectrum antibiotics kill normal gut microbiota, allowing overgrowth of C. diff bacteria and toxin production
B) Broad-spectrum antibiotics kill normal gut microbiota, allowing overgrowth of C. diff bacteria and toxin production
Correct: The normal gut flora provides a protective barrier against colonisation by pathogens like C. diff. When broad-spectrum antibiotics kill off these commensal bacteria, it disrupts this protective balance, enabling C. diff to proliferate, release toxins, and cause disease.
Explanation:
A) Antibiotics lead to increased production of C. diff spores, causing overgrowth in the intestinal tract
- Incorrect: Antibiotics do not directly stimulate increased production of C. diff spores. The overgrowth and spore formation occur because of alterations in the gut environment due to disrupted microbiota balance.
C) Antibiotics directly induce mutations in C. diff bacteria, making them pathogenic
- Incorrect: Antibiotics do not cause mutations that make C. diff pathogenic. The pathogenicity of C. diff is primarily related to its toxin production, which is facilitated by changes in the microbiome rather than by direct genetic changes.
D) C. diff colonises the gut during antibiotic therapy by adhering to damaged mucosa caused by the antibiotics
- Incorrect: Although C. diff can adhere to the gut mucosa, the primary issue is the disruption of normal flora, not necessarily direct mucosal damage. This altered gut microbiota landscape allows C. diff to overgrow and produce toxins.
E) Antibiotic use leads to hypersecretion of gastric acid, creating a favourable environment for C. diff proliferation
- Incorrect: Antibiotic use is more commonly associated with reduced stomach acid (e.g., due to concurrent proton pump inhibitor use). However, hypersecretion of gastric acid is not a factor in C. diff infections, which primarily result from changes to the gut flora.
Question 63:
Correct Answer: A) TLR 2
Correct: TLR 2 plays a crucial role in recognizing lipoproteins and lipoteichoic acids in GRAM POSITIVE BACTERIA, which are found in the cell wall of Staphylococcus aureus (this is gram positive). This receptor is key for initiating the innate immune response to Staphylococcus infections by detecting components of the bacterial cell membrane.
Explanation:
B) TLR3
- Incorrect: TLR3 recognizes double-stranded RNA, which is typically associated with viral infections, particularly those caused by RNA viruses e.g. Hep C and HIV. It does not play a significant role in detecting Staphylococcus aureus.
C) TLR4
- Incorrect: TLR4 is involved in recognizing lipopolysaccharides (LPS) found in the outer membrane of Gram-negative bacteria e.g. N.meningitidis. Staphylococcus aureus is Gram-positive and lacks LPS, TLR4 is not directly involved in recognizing Staphylococcus aureus.
D) TLR5
- Incorrect: TLR5 recognizes flagellin, a protein found in the flagella of motile bacteria. However, Staphylococcus aureus is typically non-motile and does not express flagellin, making TLR5 irrelevant for its detection.
E) TLR7
- Incorrect: TLR7 detects single-stranded RNA, primarily in the context of viral infections, particularly RNA viruses like influenza. It does not play a role in detecting Staphylococcus aureus, a gram positive bacterial pathogen.
Question 64:
Correct Answer: D) Streptococcus pyogenes
Correct: Streptococcus pyogenes is a Gram-positive coccus that typically appears as purple cocci in chains under Gram stain. It is beta-hemolytic on blood agar, producing a clear disc around colonies due to full hemolysis of red blood cells. This matches the description provided in the question.
Explanation:
A) Staphylococcus aureus
- Incorrect: Staphylococcus aureus is a Gram-positive coccus, but it typically appears in clusters rather than pairs and chains. It is also beta-hemolytic on blood agar (producing a clear zone of hemolysis), which is not the case with the described alpha-hemolytic pattern.
B) streptococcus pneumoniae
- Incorrect: Streptococcus pneumoniae is a Gram-positive coccus that typically appears as lancet-shaped and in chains under Gram stain. However It is alpha-hemolytic on blood agar, producing a greenish discoloration around colonies due to partial hemolysis of red blood cells. Whereas in the question it mentions a CLEAR disc therefore meaning it is a beta haemolytic streptococcus therefore cannot be S. pneumoniae.
C) Escherichia coli
- Incorrect: Escherichia coli is a Gram-negative rod, not a Gram-positive coccus. It also does not form pairs or chains, and it is generally non-hemolytic or beta-hemolytic on blood agar, depending on the strain.
E) Klebsiella pneumoniae
- Incorrect: Klebsiella pneumoniae is a Gram-negative rod that forms large, mucoid colonies on agar. It does not appear as pairs or chains of Gram-positive cocci and is typically non-hemolytic on blood agar. This is a common hospital UTI acquired due to frequent catheter use.
Question 65:
Correct Answer: C) Campylobacter jejuni
- Correct: Campylobacter jejuni is a common cause of bacterial gastroenteritis, especially associated with consumption of undercooked poultry. It appears as curved, Gram-negative rods with a characteristic “gull-wing” or “comma-shaped” morphology under the microscope. It often causes bloody diarrhea, abdominal cramping, and fever. It is also a common cause of Guillan Barre syndrome (GBS). it is an OBLIGATE HUMAN pathogen
Explanation:
A) Escherichia coli (E. coli)
- Incorrect: While some strains of E. coli can cause gastrointestinal symptoms, such as bloody diarrhea, they are typically identified as straight rods (not curved) on Gram stain. The “gull-wing” appearance and the characteristic bacterial growth patterns suggest Campylobacter jejuni rather than E. coli. Furthermore it is not typically associated with undercooked poultry.
B) Norovirus
- Incorrect:whilst norovirus does produce the symptoms of diarrhea, vomiting and abdominal pain, it is a virus not a bacteria and therefore cannot be one of the options as the question states it is a gram negative rod.
D) Shigella dysenteriae
- Incorrect: Shigella dysenteriae causes dysentery with bloody diarrhea but is characterized by small, non-motile, Gram-negative rods that do not exhibit the “gull-wing” shape. It is usually spread through contaminated food or water, but its morphology differs from Campylobacter jejuni.
E) Clostridium difficile
- Incorrect: Clostridium difficile causes antibiotic-associated diarrhea and pseudomembranous colitis, but it is a Gram-positive, spore-forming rod, and does not exhibit the curved morphology typical of Campylobacter jejuni. The infection is often associated with recent antibiotic use.
Question 66:
Correct Answer: B) Trichophyton rubrum
Correct: Trichophyton rubrum is a dermatophyte fungus commonly associated with superficial skin infections such as athlete’s foot, ringworm, and nail infections. The characteristic branching, septate hyphae seen on microscopy and the red colony color on fungal culture are key identifiers of this species.
Explanation:
A) Candida albicans
- Incorrect: Candida albicans is a yeast that typically causes infections like thrush or vaginal yeast infections. It is not a common cause of dermatophytosis, and its culture would not show branching hyphae. It is more often seen as a commensal organism and in cases of immunocompromise.
C) Aspergillus fumigatus
- Incorrect: Aspergillus fumigatus is an opportunistic mold that can cause pulmonary infections, particularly in immunocompromised individuals. It does not typically cause superficial skin infections, and its colonies are often greenish, not red.
D) Malassezia furfur
- Incorrect: Malassezia furfur is a yeast that causes conditions like tinea versicolor (pityriasis versicolor), characterized by hypo- or hyperpigmented patches on the skin. It does not form the typical branching, septate hyphae seen with dermatophytes like Trichophyton species.
E) Cryptococcus neoformans
- Incorrect: Cryptococcus neoformans is a yeast that typically causes systemic infections, particularly meningitis, in immunocompromised individuals. It is not associated with superficial skin infections, and its morphology differs from that of dermatophytes.
Question 67:
Correct Answer: B) Candida albicans
Correct: Candida albicans is the most common cause of vaginal candidiasis, especially in diabetic and immunocompromised individuals. The clinical features described (vaginal itching, white discharge, and erythema) along with the characteristic budding yeast and pseudohyphae seen on KOH preparation strongly suggest a Candida infection. Candida albicans is the most prevalent species causing this condition.
Explanation:
A) Aspergillus fumigatus
- Incorrect: Aspergillus fumigatus is a mold typically associated with pulmonary infections, particularly in immunocompromised patients. It is not a common cause of vaginal infections, and its morphology on KOH preparations is different from the budding yeast and pseudohyphae characteristic of Candida.
C) Trichomonas vaginalis
- Incorrect: Trichomonas vaginalis is a protozoan parasite that causes trichomoniasis, characterized by a frothy, greenish discharge with a fishy odor. The discharge in this patient is described as white and cottage cheese-like, and KOH preparation for trichomoniasis would show motile organisms, which is not consistent with the diagnosis.
D) Gardnerella vaginalis
- Incorrect: Gardnerella vaginalis is associated with bacterial vaginosis, which typically presents with a thin, grayish discharge and a characteristic fishy odor. It does not cause the thick white discharge or the typical yeast and pseudohyphae seen with Candida on KOH preparation.
E) Human papillomavirus (HPV)
- Incorrect: Human papillomavirus (HPV) is associated with genital warts and cervical dysplasia, but it does not cause the symptoms of vaginal discharge, itching, and erythema. HPV does not appear as yeast or pseudohyphae under KOH examination.
Question 68:
Correct Answer: C) Mucor species
Correct: Mucor species (a type of zygomycetes) are the most common cause of mucormycosis. They are characterized by broad, non-septate hyphae with right-angle branching, which is a distinguishing feature in microscopic examination. Mucormycosis often affects diabetic and immunocompromised patients and can involve the sinuses, eyes, and brain, as seen in this case. They also typically present with BLACK fungus

Explanation:
A) Aspergillus fumigatus
- Incorrect: Aspergillus fumigatus causes aspergillosis, typically in immunocompromised individuals. It is characterized by septate hyphae with acute-angle branching, not the broad, non-septate hyphae with right-angle branching seen in mucormycosis. While both fungi can cause sinus infections, the microscopy features differ significantly.
B) Candida albicans
- Incorrect: Candida albicans is a yeast that primarily causes mucosal infections like oral thrush, vaginal candidiasis, and systemic infections in immunocompromised individuals. It does not form the broad, non-septate hyphae with right-angle branching seen in mucormycosis.
D) Histoplasma capsulatum
- Incorrect: Histoplasma capsulatum causes histoplasmosis, which primarily affects the lungs and can disseminate, particularly in immunocompromised patients. The organism forms small, intracellular yeasts, not broad, non-septate hyphae. The presentation and morphology do not match mucormycosis.
E) Cryptococcus neoformans
- Incorrect: Cryptococcus neoformans is a yeast that typically causes meningitis in immunocompromised individuals, especially those with HIV/AIDS. It is not associated with the sinus infections or necrotic tissue seen in mucormycosis, and its microscopic appearance differs (it forms encapsulated yeasts rather than hyphal structures).
Question 69:
Correct Answer: C) Plasmodium falciparum
Correct: Plasmodium falciparum is the most common and severe cause of malaria in sub-Saharan Africa. It presents with fever, anemia, thrombocytopenia, splenomegaly, and can have complications such as jaundice. Blood smear typically shows ring forms and may show crescent-shaped gametocytes. This is the best fit for the patient’s travel history and symptoms.
Explanation:
A) Giardia lamblia
- Incorrect: Giardia lamblia causes giardiasis, characterized by chronic diarrhea, abdominal cramps, bloating, and malabsorption. It is a common cause of traveler’s diarrhea but does not present with fever, splenomegaly, or hematologic abnormalities like anemia and thrombocytopenia. Blood smears do not show Giardia as it affects the gastrointestinal tract, not the bloodstream.
B) Toxoplasma gondii
- Incorrect: Toxoplasma gondii typically causes toxoplasmosis, which may lead to flu-like symptoms, but it is less common in returning travelers unless they consumed undercooked contaminated meat or were exposed to cat feces. It does not cause malaria-like symptoms or have the characteristic findings on blood smears, and it is not common in West Africa travel exposure scenarios.
D) Cryptosporidium parvum
- Incorrect: Cryptosporidium parvum causes cryptosporidiosis, which primarily presents as watery diarrhea, often in immunocompromised individuals or travelers. It does not cause fever, anemia, or splenomegaly and is not identified in blood smears but rather in stool samples via acid-fast staining.
E) Schistosoma species
- Incorrect: Schistosomiasis caused by Schistosoma species typically presents with hematuria (urinary schistosomiasis) or gastrointestinal symptoms (intestinal schistosomiasis) after exposure to freshwater infested with cercariae. Acute schistosomiasis (Katayama fever) can cause systemic symptoms but does not match this presentation of fever, anemia, and splenomegaly seen in malaria. Diagnosis involves detecting eggs in urine or stool, not blood smears.
Question 70:
Correct Answer: B) Rapid reassortment of gene segments between different influenza strains (antigenic shift)
Correct: Antigenic shift occurs when two different influenza strains exchange genetic material, creating a new subtype to which humans have little or no pre-existing immunity. This can lead to pandemics due to the sudden emergence of a novel strain, often involving zoonotic transmission or reassortment with avian or swine influenza viruses.
Explanation:
- Antigenic Drift are in Seasonal Epidemics– These surface glycoproteins can mutate (it will still, for example, be HA9 NA2, but MUTATED SLIGHTLy
- Antigenic Shift are in Pandemics– This is when the surface glycoproteins change COMPLETELY (e.g. HA9 NA2 has now changed to HA8 NA2).
A) Gradual accumulation of point mutations in the hemagglutinin (HA) and neuraminidase (NA) genes (antigenic drift)
- Incorrect: Antigenic drift refers to minor changes caused by mutations in the influenza virus’s surface proteins (HA and NA). It is responsible for seasonal influenza epidemics and the need for annual vaccine updates, but it does not lead to pandemics.
C) Increased virulence due to the development of antiviral resistance
- Incorrect: While antiviral resistance can make treatment more challenging, it is not the primary factor leading to influenza pandemics. Resistance does not cause sudden global outbreaks or create new strains with widespread immunity gaps.
D) Widespread distribution of influenza A and B strains in unvaccinated populations
- Incorrect: Seasonal influenza often affects unvaccinated populations, contributing to annual epidemics. However, pandemics are driven by the emergence of novel strains (often influenza A) due to antigenic shift, not simply by existing strain prevalence.
E) Direct person-to-person transmission through respiratory droplets
- Incorrect: Direct transmission is how influenza spreads, contributing to both seasonal epidemics and pandemics. However, it does not explain why pandemics occur; the underlying reason for pandemics is the sudden appearance of a new strain due to antigenic shift.
Question 71:
Correct Answer: E) Hepatitis B virus (HBV)
Correct: Chronic hepatitis B is a DNA viral infection characterized by persistent infection with elevated liver enzymes and potential symptoms like fatigue, low-grade fever, and jaundice. It often has an asymptomatic or minimally symptomatic acute phase, followed by a chronic carrier state or active infection, matching the patient’s history and findings. Hepatitis B viruses have closed circular DNA (ccDNA) and when acquired in adults they tend to be symptomatic but have the virus cleared* faster (‘cleared’ the virus, the virus is still present in the human body – it has just been incorporated into the human genome. It can become re-activated during immunosuppressive treatments. ) whereas in children they tend to be asymptomatic and tend to have a chronic infection/ more time for the virus to be cleared.
Explanation:
A) Epstein-Barr virus (EBV)
- Incorrect: EBV is commonly associated with infectious mononucleosis and can establish latency in B cells. However, chronic active EBV infection is rare and does not typically present with ongoing liver enzyme elevation and jaundice as seen in chronic hepatitis B. EBV-related conditions like chronic fatigue syndrome differ from chronic HBV manifestations.
B) Human immunodeficiency virus (HIV)
- Incorrect: HIV is an RNA retrovirus (contains reverse transcriptase) causes chronic infection characterized by progressive immunosuppression due to it infecting CD4 cells.While patients may experience fatigue and low-grade fever, HIV does not typically present with jaundice or directly elevate liver enzymes unless secondary infections or comorbidities like hepatitis are involved.
C) Rotavirus
- Incorrect: Rotavirus primarily causes acute gastroenteritis, especially in children. It does not persist chronically or affect the liver, and it is not known to cause chronic infections or jaundice in adults.
D) Influenza virus
- Incorrect: Influenza virus causes acute, self-limiting respiratory infections. It does not establish chronic infection and is not associated with long-term liver enzyme elevation or chronic symptoms like fatigue or jaundice. It is an acute infection.
Question 72:
Correct Answer: D) HSV-3
Correct: HSV-3, known as Varicella Zoster Virus (VZV), causes chickenpox in primary infections and shingles upon reactivation. Shingles is characterized by a painful, unilateral vesicular rash in a dermatomal distribution. The burning sensation and dermatomal pattern strongly suggest shingles.
Explanation:
A) HSV-1 (Herpes Simplex Virus type 1, oral herpes)
- Incorrect: HSV-1 primarily causes oral herpes and can manifest as cold sores. While it can rarely cause genital infections, it does not typically cause a dermatomal rash or reactivation pattern similar to shingles (caused by VZV/HSV-3). Reactivated HSV-1 infections are not limited to one dermatome. HSV1 can also cause viral encephalitis.
B) HSV-5
- Incorrect: HSV-5, or Cytomegalovirus (CMV), can cause significant disease in immunocompromised patients but typically presents with systemic symptoms or gastrointestinal, ocular, or other systemic involvement. It does not cause a localized dermatomal rash like shingles.
C) HSV-4
- Incorrect: HSV-4 is Epstein-Barr Virus (EBV), commonly associated with infectious mononucleosis and linked to certain cancers (e.g., Burkitt lymphoma, nasopharyngeal carcinoma). EBV does not cause vesicular rashes or reactivation in a dermatomal pattern.
E) HSV-2 (Herpes Simplex Virus type 2, genital herpes)
- Incorrect: HSV-2 predominantly causes genital herpes and may cause recurrent painful genital sores. While HSV-2 can affect other areas (such as in immunocompromised patients), it does not produce a dermatomal vesicular rash like the presentation seen with shingles.HSV2 can also cause viral meningitis.
Question 73:
Correct Answer: E) Oral polio vaccine (OPV)
Correct: The oral polio vaccine (OPV) contains live, attenuated poliovirus strains. These strains are weakened but still capable of stimulating a strong and long-lasting immune response. This is why it is classified as a live vaccine, unlike the inactivated polio vaccine (IPV). this is a live attenuated single stranded RNA vaccine
Explanation:
A) Pertussis vaccine
- Incorrect: The pertussis vaccine is part of the DTaP (diphtheria, tetanus, and acellular pertussis) combination and uses inactivated components of Bordetella pertussis. It is not a live vaccine.
B) Human papillomavirus (HPV) vaccine
- Incorrect: The HPV vaccine is made from virus-like particles (VLPs) that mimic the virus but contain no genetic material. This makes it a subunit vaccine, not a live attenuated vaccine.
C) Hepatitis B vaccine
- Incorrect: The hepatitis B vaccine is a subunit vaccine composed of recombinant hepatitis B surface antigen (HBsAg). It does not contain live virus and is considered an inactivated vaccine.
D) Pneumococcal vaccine
- Incorrect: The pneumococcal vaccine (e.g., PCV13, PPSV23) is either a conjugate vaccine or a polysaccharide vaccine, both of which are inactivated. They contain purified capsular polysaccharides from Streptococcus pneumoniae.
Question 74:
Correct Answer: C) Fluoroquinolones
Correct: Fluoroquinolones, such as ciprofloxacin, are bactericidal antibiotics that target DNA gyrase (topoisomerase II) and topoisomerase IV, enzymes involved in DNA replication and supercoiling. By inhibiting these enzymes, fluoroquinolones prevent DNA replication and transcription in bacteria. As fluoroquinolones binds to DNA gyrase meaning DNA gyrase enzyme nicks the bacterial DNA but is unable to reseal it. Bacterial DNA then uncoils rapidly and becomes too large for the cell – the bacterium explodes.
Explanation:
A) Penicillin
- Incorrect: Penicillin is a beta-lactam antibiotic that targets bacterial cell wall synthesis by inhibiting the enzyme transpeptidase, which is involved in cross-linking peptidoglycan layers. It does not target DNA gyrase.
B) Tetracycline
- Incorrect: Tetracycline is an antibiotic that inhibits protein synthesis by binding to the 30S ribosomal subunit, preventing the attachment of tRNA to the ribosome. It does not act on DNA gyrase.
D) Erythromycin
- Incorrect: Erythromycin is a macrolide antibiotic that inhibits protein synthesis by binding to the 50S ribosomal subunit. It does not target DNA gyrase or affect DNA replication.
E) Vancomycin
- Incorrect: Vancomycin is a glycopeptide antibiotic that inhibits bacterial cell wall synthesis by binding to the precursors of peptidoglycan, preventing their incorporation into the cell wall. It does not target DNA gyrase.
Question 75:
Correct Answer: B) The bacterium alters the penicillin-binding proteins (PBPs) to reduce the effectiveness of penicillin.
Correct: Streptococcus pneumoniae develops penicillin resistance primarily by altering the structure of its penicillin-binding proteins (PBPs). These proteins are the target of penicillin, and changes in their structure reduce the binding of the antibiotic, making it less effective at inhibiting cell wall synthesis.
Explanation:
A) The bacterium produces beta-lactamase enzymes that break down penicillin.
- Incorrect: While beta-lactamase production is a common mechanism of resistance in many bacteria (such as Staphylococcus aureus), Streptococcus pneumoniae typically develops resistance to penicillin through changes in penicillin-binding proteins (PBPs) rather than through beta-lactamase production.
C) The bacterium alters its ribosomal binding site to prevent antibiotic binding.
- Incorrect: This mechanism of resistance is more common in bacteria resistant to macrolides (e.g., erythromycin), which inhibit protein synthesis. Streptococcus pneumoniae’s resistance to penicillin is not related to changes in the ribosomal binding site.
D) The bacterium pumps out penicillin using efflux pumps.
- Incorrect: While efflux pumps are a common resistance mechanism in some bacteria (such as Pseudomonas aeruginosa and Escherichia coli), Streptococcus pneumoniae primarily resists penicillin through modifications to penicillin-binding proteins, not by pumping out the drug.
E) The bacterium forms a biofilm that protects it from antibiotic penetration.
- Incorrect: Biofilm formation is an important resistance mechanism for many bacteria, especially in chronic infections, but it is not the primary mechanism by which Streptococcus pneumoniae resists penicillin. The primary mechanism is the alteration of penicillin-binding proteins.
Question 76:
Correct Answer: B) Type II hypersensitivity (antibody-mediated cytotoxicity)
Correct: Patients’ symptoms align with Myasthenia Gravis, this is caused by autoantibodies that target acetylcholine receptors at the neuromuscular junction, which disrupts nerve signal transmission. This is a classic example of Type II hypersensitivity, where antibodies (IgG) bind to cell surface receptors, leading to cellular dysfunction.
Explanation:
A) Type I hypersensitivity (IgE-mediated)
- Incorrect: Type I hypersensitivity involves IgE antibodies and is typically seen in allergic reactions, such as asthma, hay fever, or anaphylaxis. Myasthenia Gravis is not related to IgE-mediated reactions.
C) Type III hypersensitivity (immune complex-mediated)
- Incorrect: Type III hypersensitivity involves immune complex deposition in tissues, leading to inflammation. It is seen in conditions like lupus ,farmer’s lung, vasculitis and serum sickness, It is not the mechanism behind Myasthenia Gravis.
D) Type IV hypersensitivity (cell-mediated, delayed-type hypersensitivity)
- Incorrect: Type IV hypersensitivity is T-cell mediated and is involved in chronic inflammation and tissue damage, as seen in conditions like contact dermatitis, Diabetes type 1 or multiple sclerosis.. However, Myasthenia Gravis is not mediated by T-cells but by autoantibodies.
E) Type V hypersensitivity (autoimmunity with stimulation of receptors)
- Incorrect: Type V hypersensitivity involves autoantibodies that stimulate receptors (as in Graves’ disease), which leads to excessive activation. Myasthenia Gravis is an example of Type II hypersensitivity, where the antibodies block receptors, inhibiting normal function, rather than stimulating them.
Question 77:
Correct Answer: C) Secondary immunodeficiency due to steroid use
Correct: Long-term steroid use (e.g., prednisone for rheumatoid arthritis) is a known cause of secondary immunodeficiency. Steroids suppress the immune system, impairing T-cell function and increasing susceptibility to infections, including fungal infections like oral candidiasis and bacterial infections (e.g., sinus infections).
A) Primary immunodeficiency
- Incorrect: Primary immunodeficiencies are genetic disorders that result in intrinsic immune system dysfunction (e.g., common variable immunodeficiency, X-linked agammaglobulinemia). This patient’s history of steroid use points to a secondary cause of immunodeficiency, not a primary one.
B) Secondary immunodeficiency due to chemotherapy
- Incorrect: Chemotherapy can cause immunosuppression by suppressing bone marrow function and reducing white blood cell production, leading to secondary immunodeficiency. However, this patient does not have a history of chemotherapy, making this option less likely.
D) HIV/AIDS-related immunodeficiency
- Incorrect: While HIV causes secondary immunodeficiency, this patient does not have any symptoms related to HIV, such as weight loss, night sweats, or a history of high-risk exposure. Without more specific clinical signs, HIV is an unlikely cause here.
E) Secondary immunodeficiency due to malnutrition
Incorrect: Malnutrition can lead to secondary immunodeficiency, but this patient does not have a history of malnutrition, weight loss, or dietary deficiencies. Therefore, this is an unlikely cause in this case.
